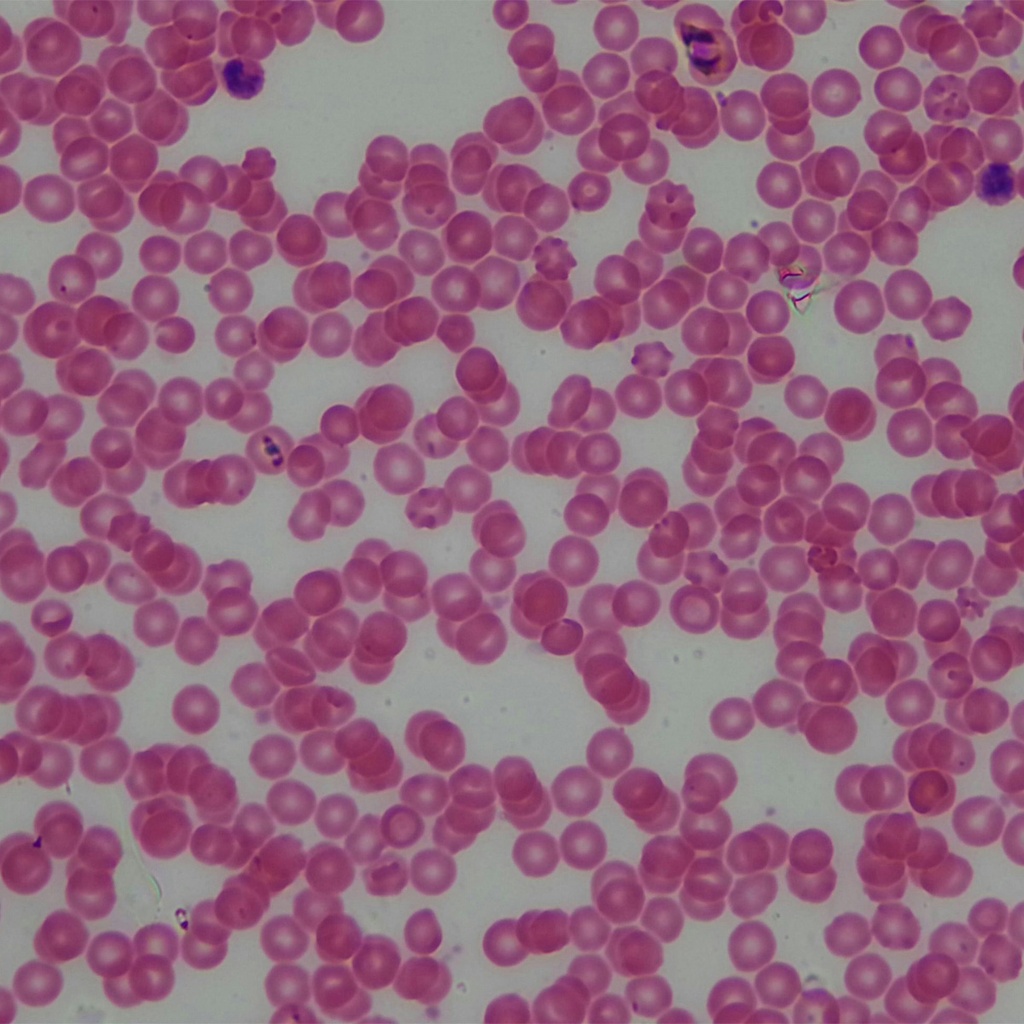
Preparación microscópica de sangre con contraste (wrigth´s)

Preparación microscópica de sangre con contraste (wrigth´s)
SKU: PR-172
PRECIOS MAS IVA, NO INCLUYEN GASTOS DE ENVÍO
*Imagen ilustrativa. El producto puede variar en color, forma o presentación.
*Los accesorios mostrados no están incluidos, salvo indicación expresa.
*Precios sujetos a cambio sin previo aviso.
*Promociones válidas hasta agotar existencias.
*Sujeto a disponibilidad en almacén.